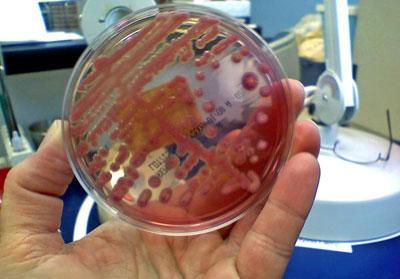
Бакпосев на инфекцию хкт

Острый гастроэнтерит – это патологический процесс, развивающийся в желудке и тонком отделе кишечника. Заболевание характеризуется наличием воспалительных очагов на слизистых оболочках органов пищеварения инфекционного и неинфекционного происхождения. Гастроэнтерит, спровоцированный вирусами, бактериями, токсичными соединениями быстро прогрессирует и может стать причиной тяжелых осложнений. После появления первых симптомов кишечной патологии следует обратиться к гастроэнтерологу для проведения тщательной диагностики и медикаментозного лечения.
Характерные особенности заболевания
Острый гастроэнтерит относится к распространенным болезням, особенно часто диагностируемым в теплое время года. Более 200 лет назад была установлена причина эпидемий среди населения – патогенные микроорганизмы. Несоблюдение правил личной гигиены, малочисленность врачей и отсутствие информации приводило к быстрому распространению заболевания. В дальнейшем выяснилось, что причинами острого гастроэнтерита могут быть возбудители аллергических реакций, алкогольные напитки, яды растительного и животного происхождения.
Острый гастроэнтерит инфекционной этиологии занимает по распространению второе место в мире среди респираторных патологий после ОРВИ и гриппа. В странах со значительной плотностью населения и дефицитом медицинского персонала регистрируется высокая смертность от потери жидкости организмом.
В основе классификации острого гастроэнтерита лежат причины развития воспалительного процесса слизистых оболочек. Специалисты выделяют следующие виды патологии:
- бактериальный;
- вирусный;
- токсический;
- алиментарный;
- аллергический;
- лекарственный.
В последнее время стремительно возросло число диагностируемых случаев болезни аллергического происхождения. Гастроэнтерологи связывают это с изменениями в рационе питания. Современный ритм жизни не позволяет уделять много времени на приготовление сбалансированной пищи, большой популярностью пользуется фастфуд и полуфабрикаты. Для увеличения срока хранения и придания вкуса производители добавляют в сосиски и булки различные химические соединения. Любое из них становится провоцирующим острый или хронический гастроэнтерит.
«Болезнь грязных рук» – именно так называется гастроэнтерит, которые возникает под действием бактерий, вирусов и токсинов. Так осуществляется передача инфекционных агентов патологического процесса. Этот способ заражения особенно актуален в семье или тесном коллективе. Источником острого гастроэнтерита является сам человек, выделяющий возбудителей воспаления в окружающую среду при кашле, чихании, сморкании. Вирусы и бактерии передаются через рукопожатие, при использовании предметов личной гигиены зараженного человека.
Врачи отмечают, что острый гастроэнтерит может быть вызван различными факторами, включая вирусные и бактериальные инфекции, а также употребление contaminated food или воды. Симптомы заболевания часто включают диарею, рвоту, боли в животе и лихорадку. Важно отметить, что у детей и пожилых людей симптомы могут проявляться более ярко и требовать особого внимания.
Лечение острого гастроэнтерита в основном направлено на восстановление водно-электролитного баланса и облегчение симптомов. Врачи рекомендуют обильное питье, а в некоторых случаях – применение регидратационных растворов. Антибиотики назначаются только в случае бактериальной инфекции. Специалисты подчеркивают, что при тяжелом течении заболевания или ухудшении состояния необходимо незамедлительно обратиться за медицинской помощью.

Гастроэнтерит инфекционного происхождения
Проникнув внутрь желудочно-кишечного тракта человека, патогенные микроорганизмы обсеменяют слизистые оболочки. Образуется несколько инфекционных очагов, укрупняющихся при отсутствии медикаментозной терапии.
Вирусы и бактерии активно размножаются, выделяя в процессе своей жизнедеятельности токсичные соединения, которые отравляют организм
. Острый инфекционный гастроэнтерит развивается под действием таких возбудителей:
- сальмонеллы;
- стафилококки;
- стрептококки;
- шигеллы;
- ротавирусы;
- норавирусы;
- простейшие.
Размножаясь в просвете желудка и тонкого кишечника, патогенные микроорганизмы способствуют избыточному продуцированию жидкости и минеральных солей. В таком состоянии у человека развивается тошнота, рвота, нарушение перистальтики. Токсичные вещества, выделяемые вирусами и бактериями, поступают в кровяное русло и разносятся по всем клеткам и тканям. Появляются симптомы обширной интоксикации: лихорадочное состояние и повышенная утомляемость.
Самым распространенным инфекционным возбудителем является ротавирус. Он становится причиной эпидемии кишечной инфекции в летнее время. После проникновения ротавирусов в организм, помимо общих симптомов острого гастроэнтерита, у человека развиваются признаки респираторных заболеваний.
К провоцирующим патологию факторам относятся:
- употребление продуктов питания, обсемененных микроорганизмами;
- несоблюдение правил личной гигиены;
- передача инфекции от зараженного человека;
- некачественная питьевая вода.
Вирусный гастроэнтерит у взрослых может возникнуть после проведения антибиотикотерапии. Противомикробные препараты уничтожают не только патогенные бактерии, но и полезную микрофлору кишечник. Это приводит к нарушению усвоения некоторых биологических активных веществ и микроэлементов. На фоне дефицита витаминов резко снижается иммунитет человека, что является благоприятной обстановкой для размножения ротавирусов.
Токсикоинфекция часто становится причиной развития острого воспалительного процесса слизистых оболочек желудочно-кишечного тракта. Использование для приготовления пищи некачественных продуктов питания приводит к активизации условно-патогенной микрофлоры в пищеварительном тракте. Отравление организма и образование инфекционных очагов происходит в таких случаях:
- неправильное хранение продуктов питания;
- предпочтение острой, жирной пищи;
- однокомпонентная диета.
Экзотоксины провоцируют размножение вирусов и бактерий, в результате чего в кровяное русло поступают энтеро- и цитотоксины, способные не только повреждать эпителиальные клетки, но вызывать симптомы общего отравления.
После проникновения внутрь желудка сальмонелл или других патогенных вирусов и микробов слизистая оболочка начинает разрушаться всего через несколько часов после употребления в пищу обсемененных продуктов.
Многие экзотоксины обладают повышенной устойчивостью к действию высоких температур. Они не погибают даже при длительной термической обработке. Чтобы предотвратить бактериальный острый гастроэнтерит следует контролировать хранение продуктов, выбрасывать упаковки с истекшим сроком годности.
Неинфекционные острые гастроэнтериты
Практически у всех людей предрасположенность к возникновению аллергических реакций закладывается еще при внутриутробном развитии. На определенной стадии формирования эмбриона происходит сбой при созревании иммунной системы. После появления ребенка на свет есть шанс, что в течение первых месяцев организм обретет способность правильно реагировать на поступающие в желудочно-кишечный тракт продукты питания.
Нарушение правил вскармливания, нерациональное введение прикормов может привести к формированию аномальных реакций на определенные продукты питания. Аллергические агенты всегда становятся причинами развития острого гастроэнтерита.
Непереносимость определенной пищи не обязательно проявляется в детском возрасте. Под воздействием определенных факторов (хронические патологии, неблагоприятная окружающая среда, эмоциональное перенапряжение) аллергия может развиться после 40-45 лет. К провоцирующим реакции сенсибилизации продуктам относятся:
- цельное молоко;
- злаки;
- куриные яйца;
- морепродукты;
- бобы.
Неинфекционный гастроэнтерит аллергического происхождения может передаваться по наследству. Если у одного из родителей была диагностирована патология, то с вероятностью в 50% у ребенка вскоре также проявится заболевание.
Токсический острый гастроэнтерит возникает после случайного или намеренного употребления ядовитых соединений. После попадания внутрь желудочно-кишечного тракта вещества абсорбируются его слизистой оболочкой. При этом повреждаются и более глубокие слои стенок желудка.
Если человек отравился едкими щелочами или кислотами, то может быть нарушена целостность органов пищеварения. Также к неинфекционным агентам относятся:
- мышьяк, цианиды;
- ртуть, хлор, фтор;
- ядра косточек вишни, абрикоса, персика;
- грибы – мухомор, бледная поганка, ложный опенок;
- некоторые виды рыб.
Проникнув в кровяное русло, токсичные соединения связываются с эритроцитами, снижая их функциональную активность по доставке молекулярного кислорода к органам. В тканях и клетках головного мозга ощущается острый дефицит кислорода, при этом в кровяном русле обнаруживается его значительная концентрация.
Помимо симптомов воспаления в кишечнике, у человека развиваются нарушения всех систем жизнедеятельности
.
К неинфекционным патологиям относится лекарственный острый гастроэнтерит. Как правило, он диагностируется у людей, которые занимаются самолечением или больны хроническими заболеваниями. Воспаление слизистых оболочек желудка и кишечника провоцирует длительный прием:
- ацетилсалициловой кислоты;
- противовоспалительных нестероидных препаратов;
- йодсодержащих лекарственных средств;
- противоопухолевых препаратов.
Все вышеперечисленные лекарства обладают способностью накапливаться в тканях и повреждать эпителиальные клетки слизистой оболочки. Они постепенно замещаются грубой соединительной тканью. На внутренней стенке желудка образуются складки и наросты.
Острый гастроэнтерит — это воспаление слизистой оболочки желудка и тонкого кишечника, которое может быть вызвано вирусами, бактериями или паразитами. Люди часто отмечают, что основными симптомами являются тошнота, рвота, диарея и боли в животе. Многие связывают развитие заболевания с употреблением contaminated food или воды, а также с недостаточной гигиеной. Лечение обычно включает восстановление водно-электролитного баланса, что особенно важно при сильной диарее. Врачи рекомендуют пить много жидкости, а в некоторых случаях назначают противорвотные и противодиарейные препараты. Важно помнить, что при тяжелых симптомах или длительном течении заболевания необходимо обратиться за медицинской помощью. Профилактика включает соблюдение правил личной гигиены и осторожность при выборе продуктов питания.

Формы острого гастроэнтерита
Продолжительность инкубационного периода острого гастроэнтерита зависит от вида инфекционного возбудителя и сопротивляемости организма к вирусам, бактериям, аллергическим агентам. Клиническая картина патологии может развиться в течение суток после проникновения патогенных микроорганизмов или ядов растительного и животного происхождения. Симптомы гастроэнтерита аллергической и токсической этиологии проявляются уже через час, а признаки инфекционного заболевания могут возникнуть и спустя несколько суток.
Опасность воспаления слизистой оболочки желудка и кишечника заключается в длительном скрытом инкубационном периоде. Это мешает проведению лечения фармакологическими препаратами на начальной стадии болезни. Также возникает риск развития тяжелых последствий: хронического гастроэнтерита, язвы желудка и двенадцатиперстной кишки.
Чтобы проведенная терапия была эффективной, гастроэнтерологи выделяют такие формы заболевания:
- Легкая. Гастроэнтерит на этой стадии проявляется нарушением работы всех органов пищеварительной системы. Симптомы не носят ярко выраженного характера, после лечения исчезают бесследно спустя 2-3 дня. В госпитализации пострадавшего нет необходимости, ему показан постельный режим и щадящая диета.
- Средняя. Воспаление этой формы проявляется признаками общей интоксикации организма. В клетках и тканях возникает дефицит жидкости, нарушается водно-электролитный баланс.
- Тяжелая. На этой стадии патологического процесса требуется срочная госпитализация пациента для проведения дезинтоксикационной терапии, снижения выраженности симптомов отравления, предотвращения дальнейшего распространения воспалительного процесса.
При отсутствии врачебной помощи возникает угроза для жизни человека. Особую опасность представляет токсический острый гастроэнтерит. Он провоцирует не только воспаление слизистых оболочек, но и их изъязвление, нарушение целостности.
Симптомы заболевания
Симптомы гастроэнтерита у взрослых различаются в зависимости от формы патологии, провоцирующего фактора, состояния иммунитета человека. На легкой или средней стадии воспаления слизистой оболочки у человека появляются такие признаки:
- нарушение перистальтики кишечника – диарея (часто с примесями свежей крови), намного реже развиваются запоры;
- расстройство работы пищеварительной системы: тошнота, рвота, метеоризм, изжога, кислая отрыжка, вздутие живота;
- резкие болезненные спазмы в эпигастральной области, распространяющиеся на бока и низ живота;
- отсутствие аппетита, резкое снижение массы тела;
- слабость, повышенная утомляемость, сонливость;
- головные боли, локализующиеся в затылочной области;
- изменение цвета кала на зеленоватый или желтоватый, в нем обнаруживаются примеси крови, слизистых веществ;
- незначительное снижение артериального давления.
По мере распространения кишечной инфекции в организме усиливается выраженность симптомов острого гастроэнтерита. Они не стихают даже на непродолжительное время, их приступы учащаются.
С помощью рвоты и диареи организм стремится избавиться от токсичных соединений и ядов. Вместе с ними уходит необходимая для всех систем жизнедеятельности жидкость. Поле попыток принять пищу признаки воспалительного процесса в желудочно-кишечном тракте усиливаются.
Если пострадавшему не была оказана медицинская помощь, заболевание принимает тяжелую, опасную для жизни человека форму. Она проявляется следующими симптомами:
- резкие скачки температуры, лихорадочное состояние, озноб, холодная испарина;
- тремор верхних и нижних конечностей;
- бледность кожных покровов, цианоз носогубной складки;
- сухость слизистых оболочек;
- нарушение координации движений, неспособность сохранять вертикальное положение;
- эмоциональная лабильность, обмороки;
- резкое снижение артериального давления и частоты сердечных сокращений.
Предупредить развитие осложнений можно только на первоначальной стадии острого гастроэнтерита. Крайне показательны для диагностики такие внешние признаки:
- потеря кожными покровами эластичности и упругости;
- сухость слизистых оболочек носа, рта и горла.
Такое состояние свидетельствует о начавшемся обезвоживании организма, выведении из него полезных биологически активных веществ и минеральных соединений. Наличие симптомов легкой стадии гастроэнтерита служит сигналом для немедленного обращения в ближайшее лечебное учреждение.
У гастроэнтерологов существует термин – синдром кишечной диспепсии. Пациенты с воспалением слизистых оболочек желудка и кишечника жалуются на давление, распирание и вздутие живота. После еды появляется урчание и переливание в эпигастральной области из-за нарушения расщепления продуктов питания на легкоусвояемые вещества.

Диагностика острого гастроэнтерита
На начальной стадии диагностирования острого гастроэнтерита доктор выслушивает описание симптомов пациентом, производит внешний осмотр, изучает заболевания в анамнезе, пальпирует область живота.
Для проведения полного обследования пострадавшему необходимо сдать образцы крови и мочи на биохимический и лабораторный анализы
. Что могут подсказать их результаты:
- обнаружение в урине повышенной концентрации минеральных соединений указывает на значительное обезвоживание организма;
- пониженное содержание в крови эритроцитов, тромбоцитов и гемоглобина позволяет заподозрить низкую сопротивляемость человека к вирусным и бактериальным инфекциям.
Для определения вида инфекционного агента и подтверждения первоначального диагноза производится посев биологического образца в питательную среду. Этот анализ помогает установить чувствительность патогенных микроорганизмов к противомикробным препаратам. С помощью тонкого эндоскопа со встроенной камерой доктор обследует желудок и тонкий кишечник. Такой метод диагностики позволяет оценить состояние слизистых оболочек, определить локализацию и размер воспалительного очага.
Лечение острого гастроэнтерита
Лечение острого гастроэнтерита начинается с устранения обезвоживания введением растворов парентерально или перорально. Такой метод терапии также способствует выведению патогенных микроорганизмов. Для устранения вирусов и бактерий используются противомикробные препараты широкого спектра действия и антибиотики. Продолжительность их приема зависит от вида возбудителя и длительности его нахождения в желудочно-кишечном тракте.
Быстрому выздоровлению способствует прием таких лекарств от гастроэнтерита:
- противорвотные;
- энтеросорбенты и адсорбенты;
- ферментативные препараты;
- пребиотики и пробиотики;
- спазмолитики и обезболивающие;
- антациды;
- жаропонижающие.
Нарушение всасывания биологически активных веществ в кишечнике приводит к появлению их дефицита в тканях. Для восполнения дисбаланса пациентам рекомендован прием комплексных витаминов и минералов. Чтобы повысить сопротивляемость организма к вирусным и бактериальным инфекциям, гастроэнтерологи назначают курсовой прием иммуностимуляторов и иммуномодуляторов.
Бесполезно лечить острую форму гастроэнтерита без соблюдения щадящей диеты. Пострадавший должен исключить на протяжении нескольких месяцев из своего рациона жирную и жареную пищу, алкогольные напитки, кофе и чай. Следует отдавать предпочтение нежирным сортам мяса и рыбы, овощам, густым супам-пюре.
Для того чтобы никогда не узнать, что такое гастроэнтерит, нужно правильно подходить к выбору продуктов питания, их термической обработке и хранению. Нельзя употреблять в пищу неизвестные грибы, необходимо соблюдать рекомендованные врачом дозировки при приеме фармакологических препаратов. Отличной профилактикой заболевания станет соблюдение мер личной гигиены, закаливание и длительные прогулки на свежем воздухе.
Вопрос-ответ
Каковы причины острого гастроэнтерита?
Алкоголь, жирная или острая пища, радиация, химические вещества, лекарственные средства, аллергическая реакция на определенные продукты.
Каковы причины гастроэнтерита?
Вирусный гастроэнтерит – инфекция вызывается при контакте человека с человеком, например, при близком контакте, рукопожатиях, при уходе за болеющими людьми или реже при употреблении загрязненной воды или пищи. На новавирус и ротавирус приходится около 70% всех острых кишечных инфекций.
Каковы симптомы гастроэнтерита?
Что такое гастроэнтерит? Гастроэнтерит – это инфекционное заболевание желудочно-кишечного тракта, сопровождающееся рвотой и поносом. Это весьма распространенное заболевание у детей младшего возраста. К симптомам гастроэнтерита относятся боли в животе, тошнота, рвота, частый жидкий стул, иногда повышение температуры.
Как лечить ротовирусный гастроэнтерит?
Лечение ротавирусного гастроэнтерита Показан прием ферментных препаратов (панкреатина), энтеросорбентов, пробиотиков. Регидратационная и дезинтоксикационная терапия в легких случаях проводится перорально, в тяжелых – парентерально в соответствии с объемом потерянной жидкости.
Советы
СОВЕТ №1
Обратите внимание на гигиену. Чтобы предотвратить острый гастроэнтерит, тщательно мойте руки перед едой и после посещения туалета. Используйте антисептики, особенно в общественных местах.
СОВЕТ №2
Следите за качеством пищи и воды. Избегайте употребления неочищенной воды и пищи из сомнительных источников. Убедитесь, что продукты свежие и правильно хранятся.
СОВЕТ №3
При первых симптомах гастроэнтерита, таких как рвота или диарея, важно поддерживать водный баланс. Пейте много жидкости, чтобы избежать обезвоживания, и используйте специальные растворы для регидратации.
СОВЕТ №4
Не занимайтесь самолечением. Если симптомы не проходят в течение нескольких дней или ухудшаются, обязательно обратитесь к врачу для получения профессиональной помощи и назначения правильного лечения.